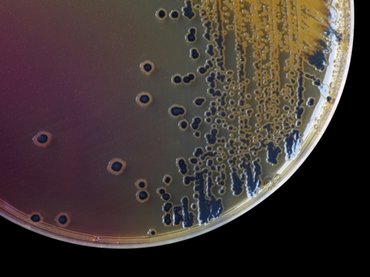
Nyári fertőzéshullám tarolhat Magyarországon: már most sok a beteg

Weborvos
Húsvéti ellenőrzés: sok élelmiszert kellett kivonni a forgalomból
2024. 04. 22. 18:01

Weborvos
Szénsavmentes vizet hívott vissza a Szentkirályi az Auchan áruházakból
2024. 03. 26. 11:55





















